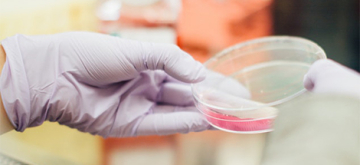
lab worker

Vlaanderen doorbreekt voor het eerst 3%-norm O&O-bestedingen

In 2019 3,35% van het bbp voor O&O
Voor het eerst doorbreekt Vlaanderen de norm van 3% van het bbp aan onderzoek en ontwikkeling. Volgens ECOOM - de instantie die de bestedingen aan onderzoek & ontwikkeling in Vlaanderen opvolgt - hebben in 2019 alle bedrijven, overheden en kennisinstellingen in Vlaanderen samen 3,35% van het bbp geïnvesteerd in onderzoek en ontwikkeling. Omgerekend komt dat op ongeveer €9,35 miljard.
Daarmee zit Vlaanderen ver boven het Europees gemiddelde en staan we op de 2de plaats in Europa. Zo laten we landen als Oostenrijk en Duitsland achter ons. Vlaanderen doet hierbij zelfs beter dan de USA. Enkel Zweden doet met 3,4% nog beter.
De komende jaren zal innovatie nog belangrijker worden, zeker in het kader van de relance en de uitdagingen rond duurzaamheid en zorg. Er komt deze legislatuur nog €250 miljoen bij voor onderzoek & ontwikkeling en daarbovenop nog eens €195 miljoen extra voor onderzoeksinfrastructuur, naast de relancemiddelen. Daarmee willen we ook de komende jaren boven die 3% blijven.
Bijna 60.000 Vlamingen werken in onderzoek
Naast de investeringen in O&O zien we ook het aantal werkenden in onderzoeksactiviteiten in Vlaanderen stijgen. In 2018 ging het om ruim 54.000 voltijdse werknemers. Een jaar later, in 2019, gaat het al om 59.283 werknemers, een stijging van 9%.